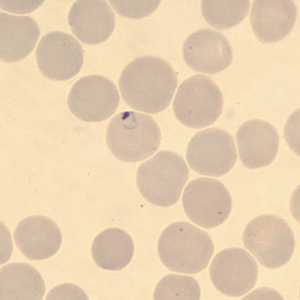
Case323_A

Monthly Case Studies - 2012
December 2012

December - 2012 - Case #337
A five-year-old boy developed loose, watery stools approximately one week after attending a birthday party for a friend.

December - 2012 - Case #338
A 42-year-old pig farmer presented to his local medical facility with intermittent diarrhea and abdominal cramping.
November 2012

November - 2012 - Case #335
A state health laboratory received Wright-stained blood films for malaria confirmation and identification. The patient had most-recently traveled to Pakistan (but had been in the U.S. for the past nine months without additional international travel).

November - 2012 - Case #336
The DPDx Team received a worm-like object collected from a child's diaper for diagnostic assistance. Grossly, the object was white, semi-flattened, and measured approximately 4.0 mm long by 2.0 mm wide.
October 2012

October - 2012 - Case #333
A 68-year-old woman underwent a routine screening mammogram, which revealed calcifications in the right breast. Biopsy specimens were collected and sent to Pathology for histological work-up.

October - 2012 - Case #334
During the laboratory component of the DPDx Diagnostic Parasitology Workshop on Intestinal Parasites, a participant made an observation on a trichrome-stained fecal smear and wanted to share with the class.
September 2012

September - 2012 - Case #331
A 35-year-old woman, who had emigrated from Azerbaijan five years previous, presented to her health care provider with abdominal pain.

September - 2012 - Case #332
A 55-year-old man presented with complaints of abdominal pain, constipation, intermittent diarrhea with blood and mucus, and blurry vision accompanied by headaches.
August 2012

August - 2012 - Case #329
A seven-year-old boy had an ova-and-parasite (O&P) stool examination performed as part of a required refugee screening. Laboratorians at the state health department observed what they believed to be a few eggs within the size range of 110-120 micrometers.

August - 2012 - Case #330
A 36-year-old man sought medical attention for sharp recurring episodes of fevers, night sweats, loss of appetite and weight-loss. He was HIV-positive but was currently on medication.
July 2012

July - 2012 - Case #327
A three-year-old boy with no known international travel history was taken to his pediatrician with diarrhea and abdominal cramping. The patient was one of several children in his day care presenting with diarrhea.

July - 2012 - Case #328
A 25-year-old woman traveled to Kenya and Uganda for three months of field work in public health entomology. Upon returning to the United States, she noticed a painful lesion on her left big toe.
June 2012

June - 2012 - Case #325
A 26-year-old man was seen by his health care provider for the sensation of something moving in his mouth. He reported a history of such sensations since he was age 12.

June - 2012 - Case #326
A 65-year-old female, who lives in northern California, had a colonoscopy performed as part of a routine screening. A foreign body was observed and subsequently removed.
May 2012
May - 2012 - Case #323
A 50-year-old man from Cambodia was admitted to the hospital for recurrent fevers. Blood specimens were collected in EDTA and sent to Hematology for routine work-up.

May - 2012 - Case #324
A 58-year-old female who had emigrated from Africa was seen by her health care provider for complications with squamous cell carcinoma of the cervix.
April 2012

April - 2012 - Case #321
A 55-year-old man from the Middle East presenting with chronic abdominal pain was seen by his health care provider.

April - 2012 - Case #322
A 28-year-old man presented to his health care provider with intermittent diarrhea, mild abdominal cramping, and low-grade fever.
March 2012

March - 2012 - Case #319
A 65-year-old patient was admitted to the hospital with fever, nausea, and vomiting after recently being treated as an outpatient for a urinary tract infection.

March - 2012 - Case #320
Stool specimens were collected from Haitian refugees as part of a screening program for intestinal parasites. Stool was collected in polyvinyl alcohol (PVA) and 10% formalin and sent to the county public health lab for routine ova-and-parasite (O&P) examination.
February 2012

February - 2012 - Case #317
A 55-year-old woman sought medical attention for a nodule on the right side of her head. The patient presented with pain on the right side of her head for the past two months.

February - 2012 - Case #318
A patient with travel to Mexico presented to his local public health facility with general abdominal discomfort. A stool specimen was collected and processed using the formalin-ethyl acetate (FEA) procedure.
January 2012

January - 2012 - Case #315
A 31-year-old man, originally from Ecuador, vomited what appeared to be a long worm-like object. The object measured 27 centimeters in length.

January - 2012 - Case #316
A 75-year-old man developed a lesion on his right forearm. The lesion developed approximately one month after returning from a trip to Costa Rica.
DPDx is an education resource designed for health professionals and laboratory scientists. For an overview including prevention and control visit www.cdc.gov/parasites/.
- Page last reviewed: September 2, 2016
- Page last updated: September 2, 2016
- Content source:
- Global Health – Division of Parasitic Diseases and Malaria
- Notice: Linking to a non-federal site does not constitute an endorsement by HHS, CDC or any of its employees of the sponsors or the information and products presented on the site.
- Maintained By:


 ShareCompartir
ShareCompartir